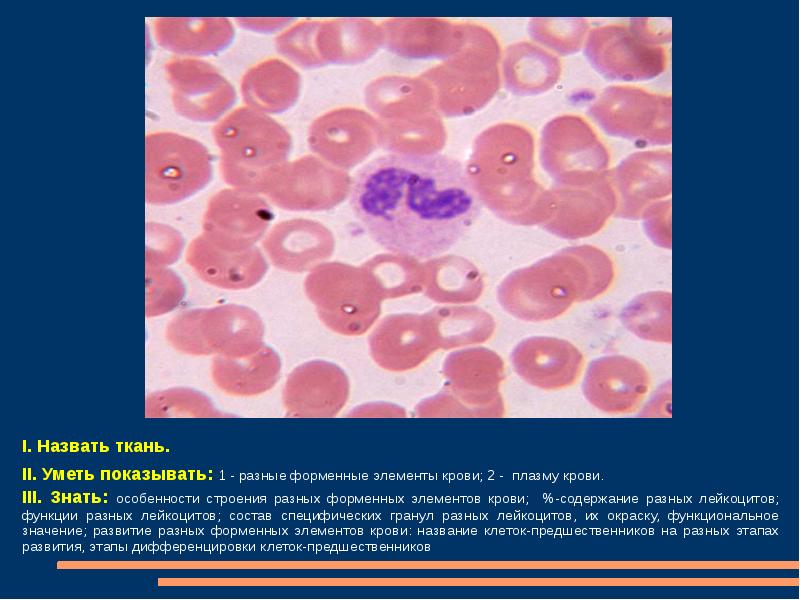

Содержимое гранул лейкоцитов
Театр ермоловой как добраться на метро
Какие почвы предпочитает ромашка
Как сделать положение рук в кс 2
Чит коды на погоду сан
Когитум для речи
Стикеры тг катя
Приказ 1 на генерального директора
Jedi fallen order настройки
Я люблю плюшки долблю
В каких странах существует традиционная экономическая система
Создание кабинета редакции в пос госпаблики
5 административное законодательство
Я люблю музыку 2024
Содержимое гранул лейкоцитов 111 фотографий